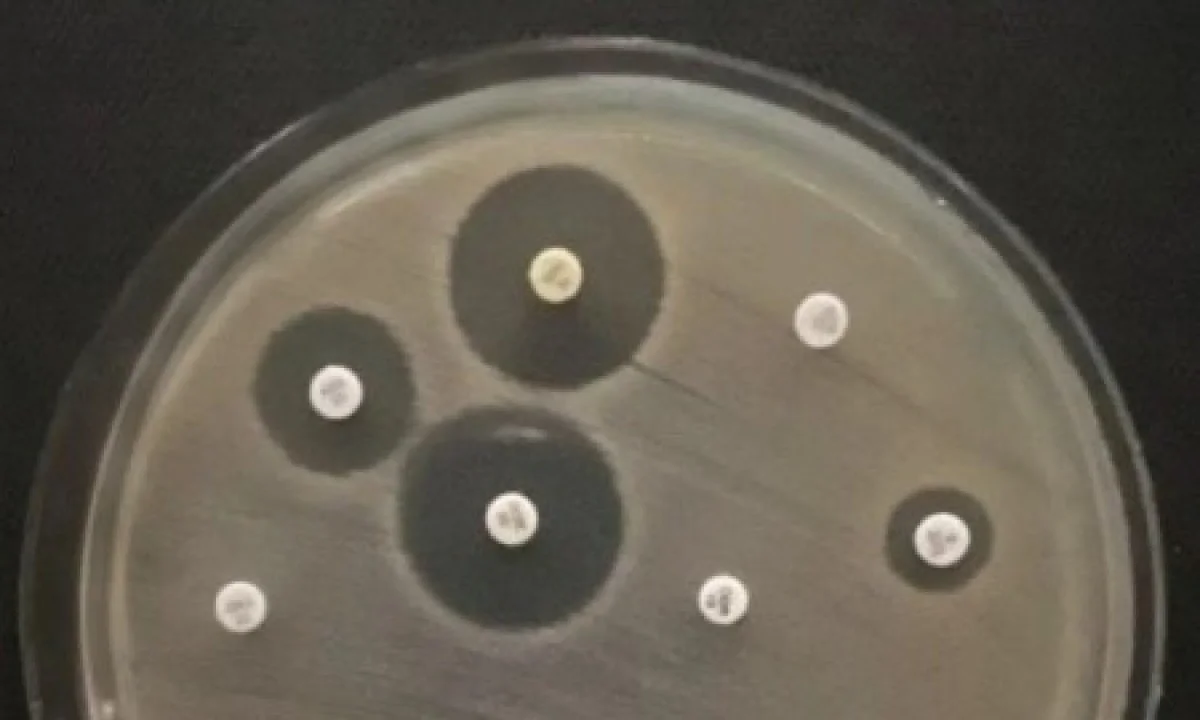

Bactérias resistentes são descobertas fora de ambiente hospitalar
Variantes resistentes à maioria das classes de medicamentos são localizadas no rio Tietê, em São Paulo, em cachorro e em infecção de pele
compartilhe
SIGA
André Julião
Bactérias resistentes à maioria das classes de antimicrobianos, antes restritas ao ambiente hospitalar, estão cada vez mais presentes na vida cotidiana. Três trabalhos publicados por pesquisadores apoiados pela Fapesp evidenciam a extensão do problema.
Um clone altamente resistente a antibióticos e ao tratamento de efluentes foi encontrado no rio Tietê, na capital paulista. O trabalho foi publicado na revista One Health.
Leia Mais
Em 2023, um clone multirresistente de Staphylococcus aureus, bactéria comum na pele humana que normalmente não é prejudicial à saúde, causou uma infecção generalizada que matou uma jovem de 18 anos. A paciente havia dado entrada no hospital pouco mais de 24 horas antes com torcicolo persistente e uma espinha indolor no rosto. Os resultados do sequenciamento genético e dos testes de resistência foram publicados em novembro de 2025 na revista The Lancet Microbe.
“Esses são apenas alguns casos mais recentes que mostram como devemos abordar essa questão seriamente do ponto de vista da Saúde Única. O uso de antimicrobianos deve ser feito com muito critério e precisamos de políticas públicas de educação para a população, assim como de diagnósticos precisos com mais rapidez”, resume Nilton Lincopan, professor do Instituto de Ciências Biomédicas da Universidade de São Paulo (ICB-USP) e coordenador dos trabalhos.
Lincopan é pesquisador do Instituto Paulista de Resistência aos Antimicrobianos (Aries), um Centro de Pesquisa, Inovação e Difusão (Cepid) da Fapesp.
O pesquisador coordena o OneBR, banco de dados genômico para auxiliar profissionais e sistemas de saúde na vigilância epidemiológica, diagnóstico, gerenciamento e controle da resistência antimicrobiana no Brasil, iniciativa também apoiada pela Fapesp.
Bactérias multirresistentes ou superbactérias, como também são chamadas, são especialmente perigosas para pacientes em unidades de terapia intensiva (UTIs), com procedimentos invasivos como ventilação mecânica ou em tratamento de câncer, por exemplo. No entanto, podem também causar infecções graves em pessoas saudáveis, especialmente crianças, cujo sistema imune ainda está em formação.
Rio Tietê
A bactéria coletada no rio Tietê, da espécie Acinetobacter baumannii, apresentava não apenas genes de resistência a antibacterianos, como também de virulência, uma característica cada vez mais vista pelos especialistas. “Há pouco tempo, encontrávamos bactérias que eram ou resistentes ou virulentas. Agora estamos detectando algumas que têm esses dois atributos, o que torna a administração da infecção ainda mais difícil”, conta Lincopan.
A coleta foi realizada pela Companhia Ambiental do Estado de São Paulo (Cetesb) como parte do monitoramento realizado pelo projeto OneBR. O clone é resistente a carbapenêmicos, uma importante classe de antibióticos, o que fez a Organização Mundial da Saúde (OMS) categorizar essas linhagens, encontradas no mundo todo, como um patógeno de prioridade crítica.
A hipótese mais plausível para a chegada da bactéria no rio é por meio de efluentes hospitalares. Outros estudos já haviam indicado que a linhagem pode ser resistente também aos tratamentos de resíduos e mesmo a produtos de limpeza.
“Além de novos antibióticos, será necessário desenvolver nos próximos anos novos tratamentos de efluentes, que evitem que esses patógenos cheguem à natureza, um problema também em outros rios urbanos do mundo”, diz Lincopan.
Participaram do estudo o aluno de iniciação científica Guilherme Paiva, as doutorandas do Cepid Aries Thais Martins Gonçalves e Johana Becerra, do ICB-USP, orientadas por Lincopan, além dos pesquisadores do Cepid Aries Rodrigo Cayô e Ana Gales, da Escola Paulista de Medicina da Universidade Federal de São Paulo (EPM-Unifesp).
Cachorro
A presença maior das superbactérias no ambiente pode ter sido a via de contaminação de uma cadela doméstica de dois anos, da raça spitz alemão, infectada com uma linhagem resistente de Klebsiella pneumoniae conhecida pela sigla ST323. O animal foi admitido em um hospital veterinário com uma gastroenterite hemorrágica severa, provavelmente após ingerir algo por acidente.
A cadela permaneceu hospitalizada por dias, enquanto a condição progredia para pancreatite severa, peritonite difusa (inflamação da membrana abdominal) e, por fim, ao óbito. Os registros veterinários revelaram que o animal já havia recebido anteriormente tratamento antimicrobiano com ampicilina/sulbactam, combinação de dois antibióticos bastante administrada, e metronidazol, em diferentes ocasiões. No momento da coleta de amostra, ela estava sendo tratada com ceftriaxona, antimicrobiano de outra classe.
“É importante ressaltar que em nenhum momento o animal foi tratado com carbapanêmicos, e mesmo assim a bactéria que provavelmente o matou era resistente a essa classe. Isso mostra a complexidade do desenvolvimento de resistência”, lembra Lincopan.
O pesquisador lembra ainda que estão se tornando comuns infecções urinárias por bactérias multirresistentes em animais domésticos. Uma hipótese levantada por ele é a transmissão por humanos, que podem levá-las para casa após longas internações hospitalares. Como gatos e cachorros tendem a lamber as pessoas e a si mesmos, podem levar bactérias da boca para o sistema urinário.
O trabalho tem como primeira autora a aluna Jéssica Taina Bordin, da Universidade Metropolitana de Santos (Unimes), orientada por Fábio Sellera, professor da mesma instituição e coordenador do estudo.
O trabalho teve apoio da FAPESP ainda por meio de bolsa para o pesquisador do Cepid Aries João Pedro Rueda Furlan, que realizou o pós-doutorado na Escola Paulista de Medicina (EPM-Unifesp). O aluno de iniciação científica Guilherme Paiva e a doutoranda do Cepid Aries Thais Martins Gonçalves, do ICB-USP, também participaram do estudo.
Acne
No caso mais chocante, uma variante de Staphylococcus aureus, bactéria comum na pele humana, causou uma sepse (infecção generalizada) numa jovem de 18 anos, em 2023.
A análise genômica e de resistência apontou que a variante é resistente a meticilina, tipo de resistência que causou 23.400 mortes nas Américas em 2019, de acordo com levantamento publicado em 2023. A linhagem encontrada, conhecida pela sigla USA300-NAE, causa justamente infecções na pele como a que iniciou o quadro da jovem brasileira.
Para Lincopan, é urgente que, para infecções comunitárias (aquelas adquiridas fora do ambiente hospitalar), o atendimento médico seja mais cauteloso, considerando a possibilidade de infecção por bactérias multirresistentes. Portanto, o diagnóstico laboratorial, que inclui o estudo do perfil de sensibilidade das bactérias aos antibióticos comercialmente disponíveis, deve preceder a prescrição. O uso indiscriminado desses medicamentos é tido como uma das principais causas para o desenvolvimento de resistência.
“Os laboratórios de apoio molecular, infelizmente restritos a universidades e grandes hospitais privados, são essenciais para identificar os patógenos de prioridade crítica causadores de infecções e orientar os tratamentos mais adequados, assim como para implementar um controle epidemiológico preventivo. É preciso aumentar as parcerias dos hospitais públicos para testagem e tornar os testes mais baratos e rápidos”, encerra o pesquisador.
“O diagnostico molecular atualmente utiliza o sequenciamento e análise de dados genômicos, que permitem identificar clones internacionais e linhagens de alto risco”, destaca o pesquisador de pós-doutorado do Cepid Aries Herrison Fontana, coautor do estudo.
Siga nosso canal no WhatsApp e receba notícias relevantes para o seu dia
A OMS considera a resistência antimicrobiana uma das grandes ameaças à saúde pública e ao desenvolvimento global. Estima-se que bactérias multirresistentes tenham sido responsáveis por 1,27 milhão de mortes e contribuído para outros 4,95 milhões de óbitos no mundo todo em 2019, ano do último grande levantamento do tipo.
